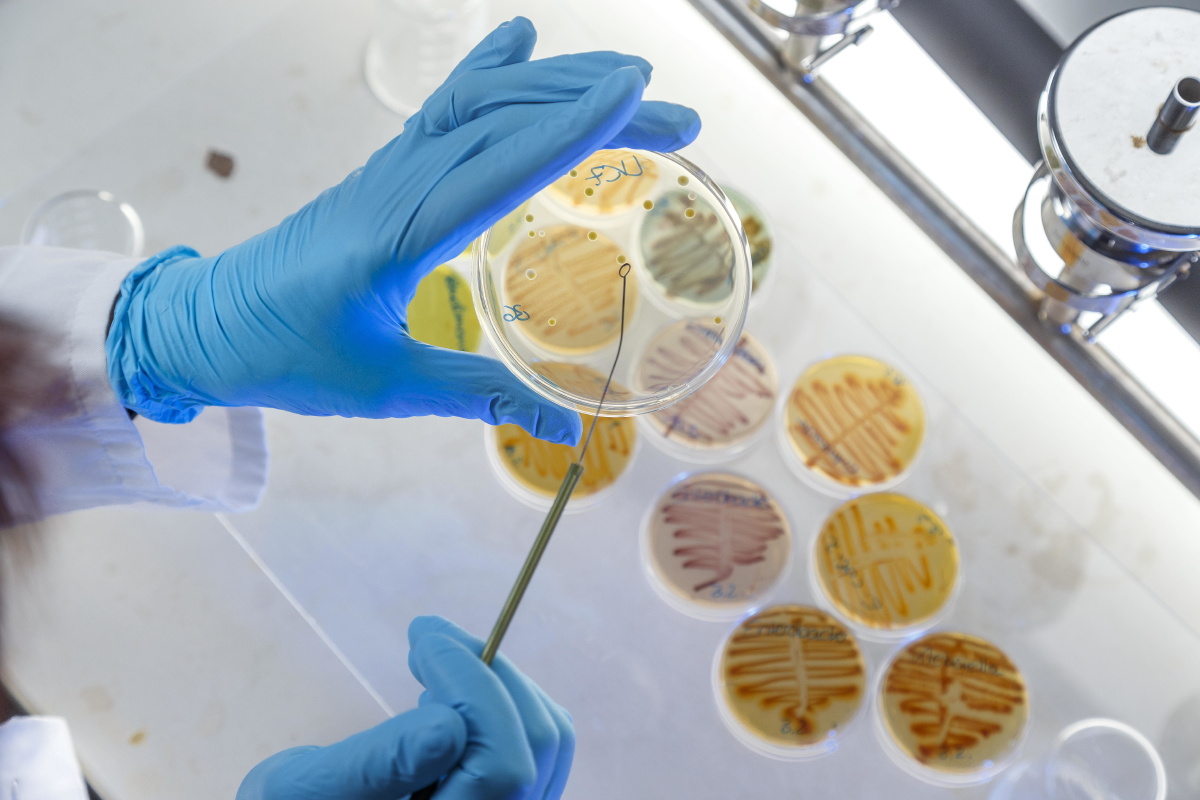
雨后的乡村小路

雨后山间小路

雨后漫步在小路上,感受空气的清新
图片尺寸640x853
雨中小路
图片尺寸1919x2830
雨后的乡村小路
图片尺寸1800x1200
雨中莲花山的小路
图片尺寸2000x2667
顺着弯曲的山间小路继续前行,雨后的路泥泞湿滑,微风带来了淡淡的泥土
图片尺寸1200x2134
雨中小路
图片尺寸1200x800
最美不过雨后的乡间小路
图片尺寸901x1200
雨后的乡村路【原创首发】
图片尺寸1022x974
雨后的小路,清新湿润.
图片尺寸2000x2667
清晨雨后小路
图片尺寸1200x1600
雨后的乡村小路
图片尺寸1200x901
湿漉漉的雨后公路
图片尺寸800x1200
雨后小路静悄悄
图片尺寸700x933
雨后漫步在小路上,感受空气的清新
图片尺寸640x853雨后的乡村土路
图片尺寸797x1200
雨后晨曦中的山间小道
图片尺寸1600x1200
小路
图片尺寸750x1000
漫步在雨中的乡间小路
图片尺寸1600x1200
弯弯小路带领我的目光前行!
图片尺寸3554x2000雨,土路,凌乱,垂直画幅,垃圾
图片尺寸800x1200